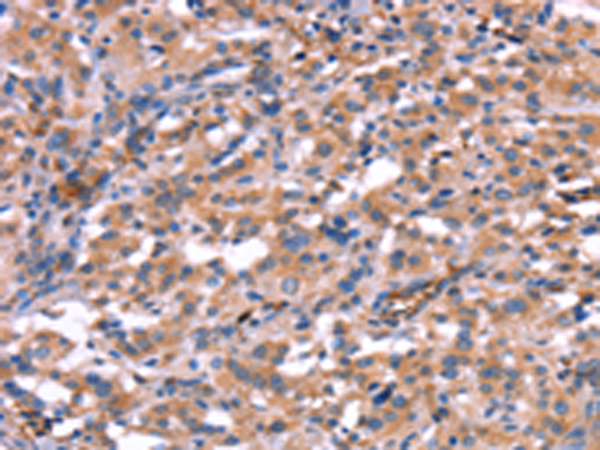

-
分类: 科研抗体货号: P04936别名: K8; HOX2; HOX2H; Hox-2.8应用: WB反应种属: Human
-
分类: 科研抗体货号: P04931别名: HMGCS应用: WB,IHC反应种属: Human
-
分类: 科研抗体货号: P04975别名:应用: WB,IHC反应种属: Human
-
分类: 科研抗体货号: P04924别名: HHL; HRY; HES-1; bHLHb39应用: WB反应种属: Human, Mouse, Rat
-
分类: 科研抗体货号: P04974别名: HsT18964应用: WB,IHC反应种属: Human
-
分类: 科研抗体货号: P04922别名: PBF; PRF1; HDBP2; PRF-1; HDBP-2; HDRF-2; Si-1-8-14应用: IHC反应种属: Human
-
分类: 科研抗体货号: P04969别名: IMB1; IPO1; IPOB; Impnb; NTF97应用: IHC反应种属: Human, Mouse, Rat
-
分类: 科研抗体货号: P04918别名:应用: WB反应种属: Human
-
分类: 科研抗体货号: P04967别名: GPAPP; IMP 3; IMP-3; IMPA3应用: IHC反应种属: Human, Mouse, Rat
-
分类: 科研抗体货号: P04992别名: KV6.3; KV10.1应用: WB,IHC反应种属: Human, Mouse, Rat

鄂公网安备42018502007531号
鄂公网安备42018502007531号

